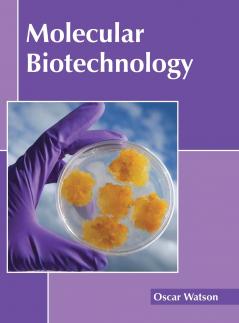
Molecular Biotechnology

English
Hardback
₹12323
(All inclusive*)
Delivery Options
Please enter pincode to check delivery time.
*COD & Shipping Charges may apply on certain items.
Review final details at checkout.
Looking to place a bulk order? SUBMIT DETAILS
About The Book
Description
Author
Molecular biotechnology is the science and practice of using laboratory methods in order to examine nucleic acids and proteins. These practices are used in many fields like medicinal science veterinary medicine agricultural science and environment. Molecular biotechnology is the amalgamation of many fields like genetics cell biology molecular biology microbiology biochemistry etc. This book present researches and studies performed by experts across the globe on the various fields related to molecular biotechnology. It picks up individual branches and explains their need and contribution in the context of the growth of this subject. Most of the topics introduced in the text cover new techniques and the applications of molecular biotechnology. It will help new researchers by foregrounding their knowledge in this branch. Students and scientists engaged in this field will find this book helpful as it compiles contributions made by experts from across the globe.
Delivery Options
Please enter pincode to check delivery time.
*COD & Shipping Charges may apply on certain items.
Review final details at checkout.
Details
ISBN 13
9781632398123
Publication Date
-23-05-2017
Pages
-244
Weight
-736 grams
Dimensions
-216x280x14.29 mm